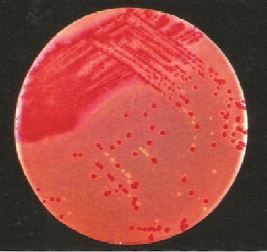

النبات

مواضيع عامة في علم النبات

الجذور - السيقان - الأوراق

النباتات الوعائية واللاوعائية

البذور (مغطاة البذور - عاريات البذور)

الطحالب

النباتات الطبية


الحيوان

مواضيع عامة في علم الحيوان

علم التشريح

التنوع الإحيائي

البايلوجيا الخلوية


الأحياء المجهرية

البكتيريا

الفطريات

الطفيليات

الفايروسات


علم الأمراض

الاورام

الامراض الوراثية

الامراض المناعية

الامراض المدارية

اضطرابات الدورة الدموية

مواضيع عامة في علم الامراض

الحشرات


التقانة الإحيائية

مواضيع عامة في التقانة الإحيائية


التقنية الحيوية المكروبية

التقنية الحيوية والميكروبات

الفعاليات الحيوية

وراثة الاحياء المجهرية

تصنيف الاحياء المجهرية

الاحياء المجهرية في الطبيعة

أيض الاجهاد

التقنية الحيوية والبيئة

التقنية الحيوية والطب

التقنية الحيوية والزراعة

التقنية الحيوية والصناعة

التقنية الحيوية والطاقة

البحار والطحالب الصغيرة

عزل البروتين

هندسة الجينات


التقنية الحياتية النانوية

مفاهيم التقنية الحيوية النانوية

التراكيب النانوية والمجاهر المستخدمة في رؤيتها

تصنيع وتخليق المواد النانوية

تطبيقات التقنية النانوية والحيوية النانوية

الرقائق والمتحسسات الحيوية

المصفوفات المجهرية وحاسوب الدنا

اللقاحات

البيئة والتلوث


علم الأجنة

اعضاء التكاثر وتشكل الاعراس

الاخصاب

التشطر

العصيبة وتشكل الجسيدات

تشكل اللواحق الجنينية

تكون المعيدة وظهور الطبقات الجنينية

مقدمة لعلم الاجنة


الأحياء الجزيئي

مواضيع عامة في الاحياء الجزيئي


علم وظائف الأعضاء


الغدد

مواضيع عامة في الغدد

الغدد الصم و هرموناتها

الجسم تحت السريري

الغدة النخامية

الغدة الكظرية

الغدة التناسلية

الغدة الدرقية والجار الدرقية

الغدة البنكرياسية

الغدة الصنوبرية

مواضيع عامة في علم وظائف الاعضاء

الخلية الحيوانية

الجهاز العصبي

أعضاء الحس

الجهاز العضلي

السوائل الجسمية

الجهاز الدوري والليمف

الجهاز التنفسي

الجهاز الهضمي

الجهاز البولي


المضادات الميكروبية

مواضيع عامة في المضادات الميكروبية

مضادات البكتيريا

مضادات الفطريات

مضادات الطفيليات

مضادات الفايروسات

علم الخلية

الوراثة

الأحياء العامة

المناعة

التحليلات المرضية

الكيمياء الحيوية

مواضيع متنوعة أخرى

الانزيمات
الحالات المرضية البكتيرية :الحالة السابعة والعشرون
المؤلف:
عبد الرزاق سليمان التومي ، محمد محمد الامام ، عبد الباسط رمضان
المصدر:
اساسيات التشخيص البكتريولوجي المعملي والسريري
الجزء والصفحة:
4-9-2016
2381
الحالات المرضية البكتيرية :الحالة السابعة والعشرون
بعد أربع وعشرون ساعة من حضور اجتماع بدأ المريض يعاني من ارتفاع في درجة الحرارة وألم في البطن وفيء واسهال. تم تجميع عينة من البراز وتنميتها على وسط غذائي اختياري وتفريقي وهو حساء selenite F المستعمرات البكتيرية النامية يعتقد انها للجنس البكتيري Salmonella Spp (الشكل رقم 1) كما تم إجراء الاختبارات المصلية والتعريف باستعمال التصنيف حسب اللاقمات الفيروسية phage typing فكانت النتيجة أن الكائن المعزول هو النوع البكتيري Salmonella enteritidis من النوع phage type 4 .
الشكل رقم 1 : المزرعة البكتيرية

الشكل رقم 2 : الاختبارات الكيموحيوية
الأسئلة :
1- اي المستعمرات البكتيرية النامية يتم التعامل معها ؟
2- كيف تتم معالجة هذا المريض؟
3- ما هو الطعام الذي قد يكون مسئولاً عن إحداث المرض؟
4- ما هي الخطوات المعملية التي يجب أن تجرى لتشخيص حالة مريض يعتقد أنه مصاب بمرض معوي؟
الإجابة :
1- يجب التعامل مع المستعمرات البكتيرية باهتة اللون والتي تدل على احتمالية وجود الجنس البكتيري Salmonella Spp أو الجنس البكتيري Shigella Spp وهما من الأجناس البكتيرية غير المخمرة لكس اللاكتوز ويتم غجراء الاختبارات الكيموحيوية لاستبعاد احتمالية أن تكو الجنس البكتيري .Pseudomonas Spp أو الجنس البكتيري Proteus Spp.
ليس للمضادات الحيوية أي دور في علاج المرضى المصابين بالنزلة المعوية نتيجة الإصابة بالجنس البكتيري . Salmonella Spp ويستعمل فقط في علاج الحالات التي يعاني فيها المريض من خلل في الجهاز المناعي أو الحالات التي أصبح فيها المرض جهازياً systemic . ويجب أن يتناول المريض السوائل والاملاح التعويضية.
2- هناك علاقة وثيقة من الناحية الوبائية بين عزل النوع البكتيري Salmonella enteritidis من النوع phage type وتناول بيض الدجاج الملوث.
3- من المفيد جداً في التحليل المعملي معرفة الأحداث التي صاحبت ظهور الأعراض حتى يتم اختيار الوسط الغذائي المناسب وذلك بناءاً على الأعراض السرسرية والكائن الدقيق المتوقع عزله.
يتم عادة تنمية عينات البراز في الأوساط الغذائي التالية : McConkey agar أو deoxycholate citrate agar (DCA) وكذلك في الوسط الغذائي حساء الـت selenine المغذي (selenite F) وعند الشك في أن تكون العينة لمريض مصاب بمرض الكوليرا يتم تنمية العينة في الوسط الغذائي (TCBS) . الشكل رقم 1.28 يظهر وجود مستعمرات بكتيرية باهتة اللون يجب ان يتم إجراء الاختبارات الكيموحيوية والمصلية لتعرفيها. الشكل رقم 2 بوضح نتيجة الاختبارات الكيموحيوية والمصلية لتعريفها . الشكل رقم 2 يوضخ النتيجة الاختبارات الكيموحيوية.
هناك أكثر من 1500 نوع من الجنس البكتيري Salmonella Spp تختلف في الأساس عن بعضها البعض من الناحية المصلية يعتبر الجدار الخلوي في الجنس البكتيري Salmonella Spp محفز مستضد ويسمى المستضد O ، وإذا كانت البكتيريا من النوع المتحرك فهي بالتأكيد تحتوي على أسواط ويسمى المستضد H . تتكون الأنواع المتعددة من الجنس البكتيري salmonella Spp من تركيبة مختلفة من المستضد O والمستضد H ويسمى التقسيم المصلي الذي يجرى على الجنس البكتيري . Salmonella Spp بــ Kaufmann scheme . بعض الانواع يتم تقسيمها أيضاً باستعمال التصنيف حسب نوع اللاقمة الفيروسية phage وهذا التعريف يفيد في الحالات التي تكون نتيجة حدث تفشي للوباء وذلك لمعرفة الإصابة.
 الاكثر قراءة في البكتيريا
الاكثر قراءة في البكتيريا
 اخر الاخبار
اخر الاخبار
اخبار العتبة العباسية المقدسة

الآخبار الصحية















 قسم الشؤون الفكرية يصدر كتاباً يوثق تاريخ السدانة في العتبة العباسية المقدسة
قسم الشؤون الفكرية يصدر كتاباً يوثق تاريخ السدانة في العتبة العباسية المقدسة "المهمة".. إصدار قصصي يوثّق القصص الفائزة في مسابقة فتوى الدفاع المقدسة للقصة القصيرة
"المهمة".. إصدار قصصي يوثّق القصص الفائزة في مسابقة فتوى الدفاع المقدسة للقصة القصيرة (نوافذ).. إصدار أدبي يوثق القصص الفائزة في مسابقة الإمام العسكري (عليه السلام)
(نوافذ).. إصدار أدبي يوثق القصص الفائزة في مسابقة الإمام العسكري (عليه السلام)


















